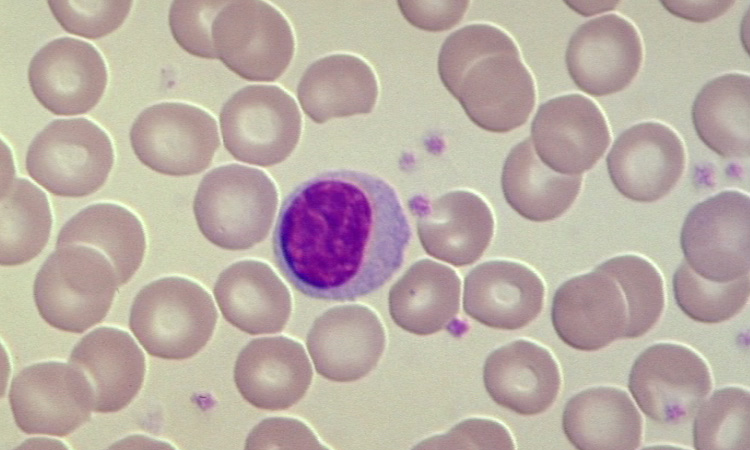
De l'organisme à la cellule - Les cellules animales - 3mn 50s

La cellule est l’entité commune à tous les êtres vivants connus, qu’ils soient pluricellulaires (formés de plusieurs cellules, comme les animaux, les plantes et les champignons), ou unicellulaires (formés d’une seule cellule, comme les protistes, les bactéries ou les archées). De taille microscopique, dans l’immense majorité des cas, la cellule représente l’unité biologique structurelle et fonctionnelle de tous les organismes vivants. L’existence des cellules n’a été démontrée que lors de l’invention du microscope, au milieu du XVIIème siècle.
A la base, chaque cellule est constituée de 3 éléments fondamentaux : une très fine membrane plasmique externe, qui la délimite. Celle-ci est remplie d’un liquide aqueux de nature complexe, le cytoplasme. Au sein du cytoplasme existe, le plus souvent, une structure qui concentre le matériel génétique de la cellule, et que l’on qualifie de noyau ou de nucléoïde, selon les cas.

x170.jpg)


 en CL x8000.jpg)

 en CL MET x8000.jpg)






 x150.jpg)






















 x100.jpg)




 x160.jpg)











































 x100.jpg)
 x200.jpg)







 x100.jpg)
 x100.jpg)
 x100.jpg)












 x200.jpg)





















 x160.jpg)
 x160.jpg)
 x160.jpg)



 x100.jpg)






















 x100.jpg)
 x100.jpg)


.jpg)
.jpg)

.jpg)

.jpg)
.jpg)

.jpg)
.jpg)









































 x100.jpg)












 x100.jpg)











 x40.jpg)






 - infographie.jpg)
 - infographie.jpg)


























